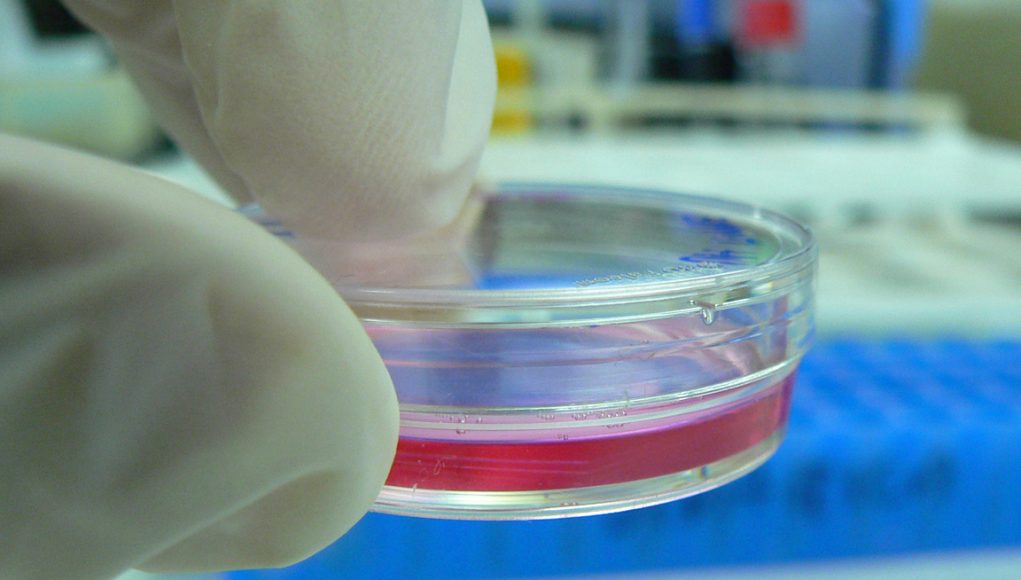

New study claims vape flavours cause heart attacks
A recently published paper from Stanford University in – where else? – the USA claims vaping, especially with flavoured e-liquid, increase the risk of heart disease. The research behind the paper was carried out by experienced researchers led by a reputable university, and there’s no reason to doubt the basic science – but, as usual, both scientists and the media are drawing conclusions that the data just don’t support.
As in many previous studies into alleged health risks of vaping, this one used cultures of endothelial cells – cells which line blood vessels. These cultures were exposed to e-liquid, then checked for health and function. The researchers found that the cells were more likely to die, showed signs of DNA damage and were less effective at doing their job.
The problem is that, in a real human body, endothelial cells don’t operate as a homogenous blob sitting in a glass culture dish. They’re protected by the body’s immune system and various other layers of defences. According to the study, vaping – particularly with flavoured liquids, especially cinnamon and menthol – increases the risk of heart disease. However, this purely theoretical risk is not being seen in the real world. Laboratory culture tests like this can give us indications of what might need more investigation; what they can’t do is justify bold claims like “vaping causes heart disease” – especially when all the evidence is that it doesn’t.
Massachusetts sues vape vendor
Following North Carolina’s controversial decision to sue JUUL Labs for “marketing to children” (although the company’s own website enforces a strict over-21 policy, more than required by federal law), the attorney general of Massachusetts has decided to sue another vaping company for the same alleged offence.
Attorney General Maura Healey announced on Thursday that she had filed a complaint in Suffolk Superior Court accusing Eonsmoke LLC of violating state law by targeting underage consumers. Eonsmoke, which is based in New Jersey, is allegedly guilty of failing to verify that purchasers are over 21 – which is a requirement in Massachusetts, but not in New Jersey – and of selling flavours like “Gummy bear” and “Cereal loops”, which many Americans seem to believe don’t taste good to adults.
Healey has a reputation as an anti-vaping activist. While this is the first time she’s actually gone to court to oppose harm reduction, she’s been heading up an investigation of the vape industry since taking office last year.
Vaping gains popularity among cancer patients – experts baffled
New research from the USA has found that people who have suffered from cancer are increasingly switching from smoking to an alternative that eliminates almost all the carcinogens. The reasons behind this are a mystery to lead author Dr Nina Sanford, who thinks it’s “concerning” that people who’ve had cancer once already are trying not to get it again.
It’s known that smoking can slow the healing process following surgery or radiotherapy, and Sanford seems to think vaping poses a similar risk. She also seems unaware of how much research has been done on vapour products, claiming “studies have just started” and that it will take decades to know if they cause cancer. Perhaps if Dr Sanford looked at the huge collection of research that has in fact been done she’d be less concerned.
FDA under pressure to be even tougher on vaping
America’s Food and Drug Administration is already notorious for its virulent opposition to tobacco harm reduction – but now a senior Democrat politician is urging the agency’s acting chief to take an even harder line.
Senator Dick Durbin (D, IL) has written to interim FDA Commissioner Ned Sharpless demanding an immediate ban on so-called “kid-friendly” e-liquid flavours, which seems to mean anything that doesn’t actually taste of tobacco. Unable to comprehend the idea that adults might also have a sense of taste, Durbin claims that flavours like JUUL Labs’ Cool Cucumber are particularly attractive to children.
Durbin is also demanding stricter enforcement of the FDA’s Deeming Regulations, which threaten to remove almost all vapour products from the US market.
Kentucky teen informants recognised for anti-vaping activities
A group of middle school students from Johnson County, Kentucky have been named “Healthy Kentucky Policy Champions” after a flurry of activity centred around setting up an anonymous hotline that lets teens inform on fellow students they think might be using e-cigs. The nine students, who claim to have spent all year pestering their classmates, have also been actively spreading anti-harm reduction propaganda and lobbying state politicians to bring in draconian new anti-vaping laws.